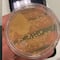
VIDEO: ¿Qué tan cochina tiene la patita tu gato? TikTok responde

¿Te has preguntado por qué tu gato te sigue a todos lados? Pues bueno, nos encontramos ante una de las mascotas más intrigantes que puede haber, pero eso no significa que no se pueda entender.
La disputa entre perros y gatos para saber quién es la mejor mascota siempre termina generando un debate entre las personas.
Una de las principales razones por las que un gato no suele ser del gusto de algunos, es porque son animales independientes con una conducta incluso opuesta a la de los perros.
Pero lo cierto es que detrás de esa apariencia y actitud autosuficiente, hay razones muy buenas por las que tu gato tiene una extraña conducta.

5 razones por las que tu gato está siguiéndote
Un gato, primero que nada, es un felino que fue domesticado a lo largo del tiempo, por lo que su conducta tiene detrás toda una serie de instintos que no van a desaparecer de la noche a la mañana.
Es por lo anterior que debes tener en cuenta estas 5 razones que explican por qué de un día para otro parece que no quiere despegarse de ti y te sigue a todas partes.
Estas, te ayudarán a entenderlo la próxima vez que lo veas hacer algo diferente:
- Está marcando su territorio. Te sigue para dejar impregnado su olor, pues siente que su dueño hace lo mismo cuando camina por ahí
- Explora su entorno. Los gatos son curiosos por naturaleza, así que al seguirte es una forma de seguir descubriendo el mundo que lo rodea
- Está “cazando”. ¿Recuerdas la parte de los instintos? Pues bueno, la caza es uno de ellos y no lo pueden evitar
- Intenta llamar tu atención. Aquí debes ponerle mucha atención a tu gato, pues muy probablemente tenga hambre, se sienta solo o requiere de que su arenero sea limpiado
- ¡Te quiere! Contrario a lo que muchos creen, un gato genera vínculos afectivos con sus dueños, por lo que son perfectamente capaces de querer
Ahora ya lo sabes. No es difícil tratar de entender a estas enigmáticas criaturas. Solamente hay que tratar a cada gato con paciencia y amor.